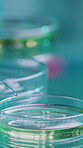
Medical, chemical and petri dish and needle in lab for biomedical engineer, enzyme study and science. Research experiment, molecular reaction and nanoparticle solution with syringe in clinic for test

Stock Photo - Tablet, glass wall and scientists in laboratory for research, project or medical study in collaboration. Teamwork, digital technology and biologists working on pharmaceutical development together.
Tablet, glass wall and scientists in laboratory for equation, project or medical study in collaboration. Teamwork, digital technology and biologists working on pharmaceutical formula together. - Stock Photo
Stock photo ID: 3346248
Stock Photo Keywords:
tablet team teamwork medical formula together study tech laboratory lab project pharmaceutical working technology scientists work digital collaboration
How do you plan to use this image?
Choose Size and Download